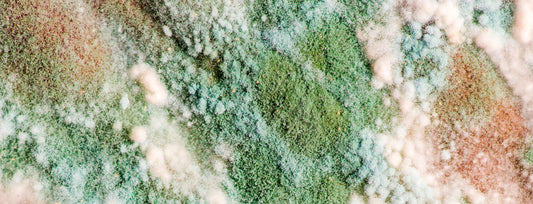

Bokashi Articles and Inspiration

What is the Best Way to Deal with Holiday Meal ...
There’s no doubt that the holidays are a time when we often end up with a lot more food wastes! Unfortunately, all these different wastes aren’t created equal (not even...
What is the Best Way to Deal with Holiday Meal ...
There’s no doubt that the holidays are a time when we often end up with a lot more food wastes! Unfortunately, all these different wastes aren’t created equal (not even...

Bokashi - Phase II Turning Your Pre-Compost In...
Bokashi offers us a great way to deal with a wide range of food wastes - including many that aren’t well suited for regular composting, such as meat and dairy...
Bokashi - Phase II Turning Your Pre-Compost In...
Bokashi offers us a great way to deal with a wide range of food wastes - including many that aren’t well suited for regular composting, such as meat and dairy...
Bokashi Gone Wrong
Tell-Tale Signs Your System Isn’t Working, and What to Do About It! Bokashi “composting” - actually a type of fermentation breakdown process - is one of the simplest (and easiest)...
Bokashi Gone Wrong
Tell-Tale Signs Your System Isn’t Working, and What to Do About It! Bokashi “composting” - actually a type of fermentation breakdown process - is one of the simplest (and easiest)...

Bokashi - A Simple, Effective Method for Benefi...
Backyard composting and vermicomposting tend to get the lion’s share of attention when it comes to composting at home, but there’s a another method that tends to fly under the...
Bokashi - A Simple, Effective Method for Benefi...
Backyard composting and vermicomposting tend to get the lion’s share of attention when it comes to composting at home, but there’s a another method that tends to fly under the...
Join the Composter's Club Newsletter
Enjoy a brand new issue every month - jam-packed with exciting updates, helpful composting resources & tips, and special offers. You'll also receive a free PDF copy of our Worm Care Guide, and a $5.00 coupon good towards your first purchase!